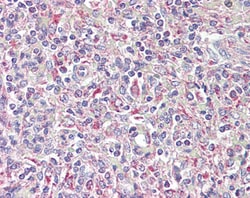
Invitrogen TRIB1 Polyclonal Antibody 100 &mu;g; Unconjugated:Antibodies,

missing translation for 'onlineSavingsMsg'
Learn More
Learn More
Invitrogen™ TRIB1 Polyclonal Antibody


Goat Polyclonal Antibody
Brand: Invitrogen™ PA5142357
This item is not returnable.
View return policy
Description
This antibody is tested in Peptide ELISA: antibody detection limit dilution 1:8,000.
TRIB1 also called gprotein coupled receptor induced, skip1, gig2, c8fwATP, functions in binding protein binding, protein kinase inhibitor activity, and protein serine/threonine kinase activities. Overexpression of TRIB1 in HeLa cells repressed the basal activity of the IL8 promoter by inhibiting AP1 activity. Overexpression of TRIB1 inhibited oncogenic Ras -driven AP1 activation and MEKK1-mediated AP1 activation. ERK activation was enhanced by TRIB1. Coimmunoprecipitation and yeast 2-hybrid assays showed that MEK1 interacted with both TRIB1 and TRIB3, and MKK4 interacted specifically with TRIB1. Cotransfection of MKK4 enhanced the level of TRIB1, indicating that the TRIB-MAPKK interaction stabilized TRIB1.
Specifications
| TRIB1 | |
| Polyclonal | |
| Unconjugated | |
| TRIB1 | |
| A530090O15Rik; C8FW; Gig2; GIG-2; G-protein-coupled receptor induced protein; G-protein-coupled receptor induced protein GIG2; G-protein-coupled receptor-induced gene 2 protein; G-protein-coupled receptor-induced protein 2; phosphoprotein regulated by mitogenic pathways; SKIP1; Trb1; TRB-1; Trib1; tribbles homolog 1; tribbles homolog 1 (Drosophila); tribbles pseudokinase 1; tribbles-like protein 1 | |
| Goat | |
| Ammonium Sulfate Precipitation | |
| RUO | |
| 10221 | |
| -20°C, Avoid Freeze/Thaw Cycles | |
| Liquid |
| Immunohistochemistry (Paraffin), Western Blot | |
| 0.5 mg/mL | |
| TBS with 0.5% BSA and 0.02% sodium azide; pH 7.3 | |
| Q96RU8 | |
| TRIB1 | |
| Peptide with sequence C-TSDQIVPEYQEDSD (aa 353-366). | |
| 100 μg | |
| Primary | |
| Human | |
| Antibody | |
| IgG |
Product Content Correction
Your input is important to us. Please complete this form to provide feedback related to the content on this product.
Product Title
Spot an opportunity for improvement?Share a Content Correction